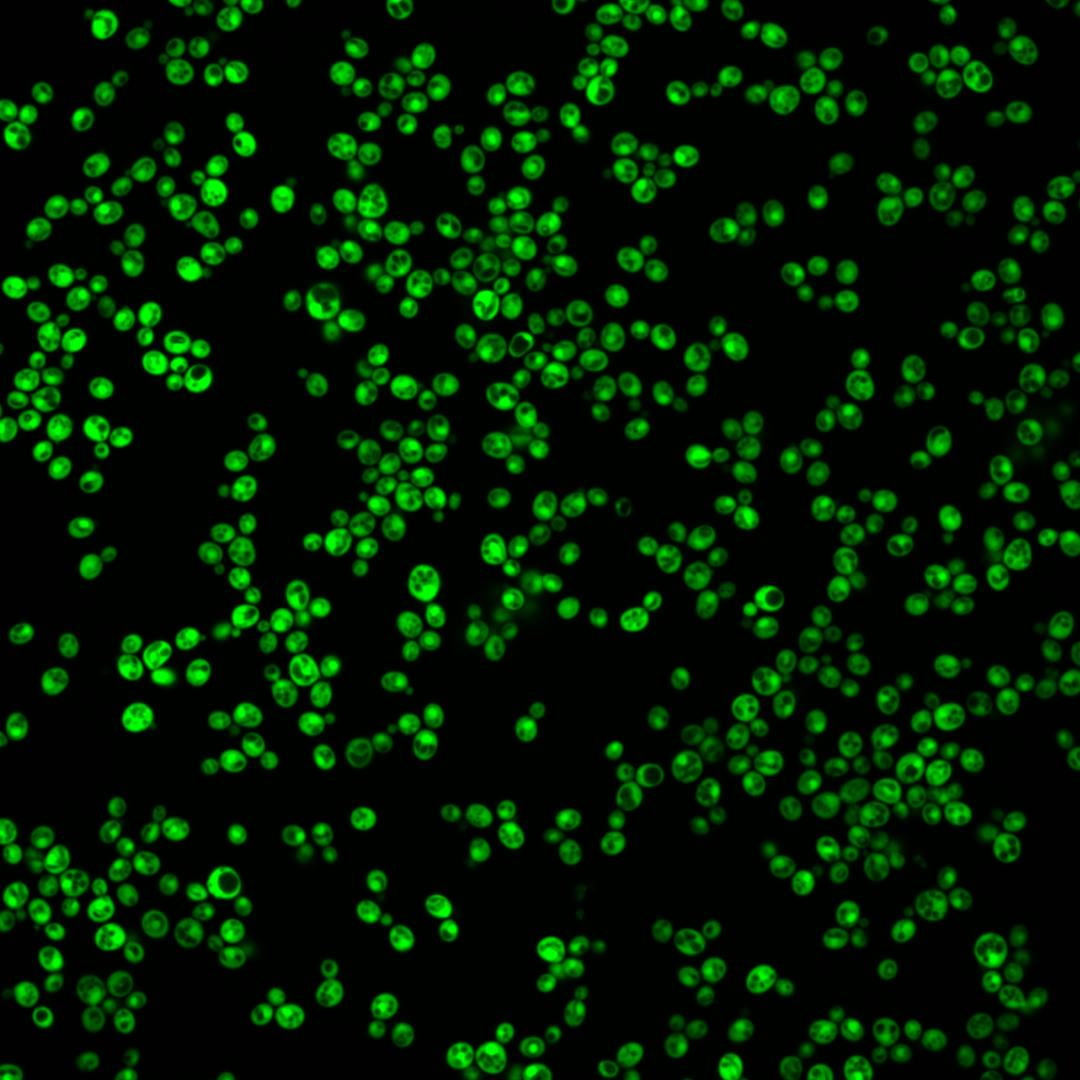
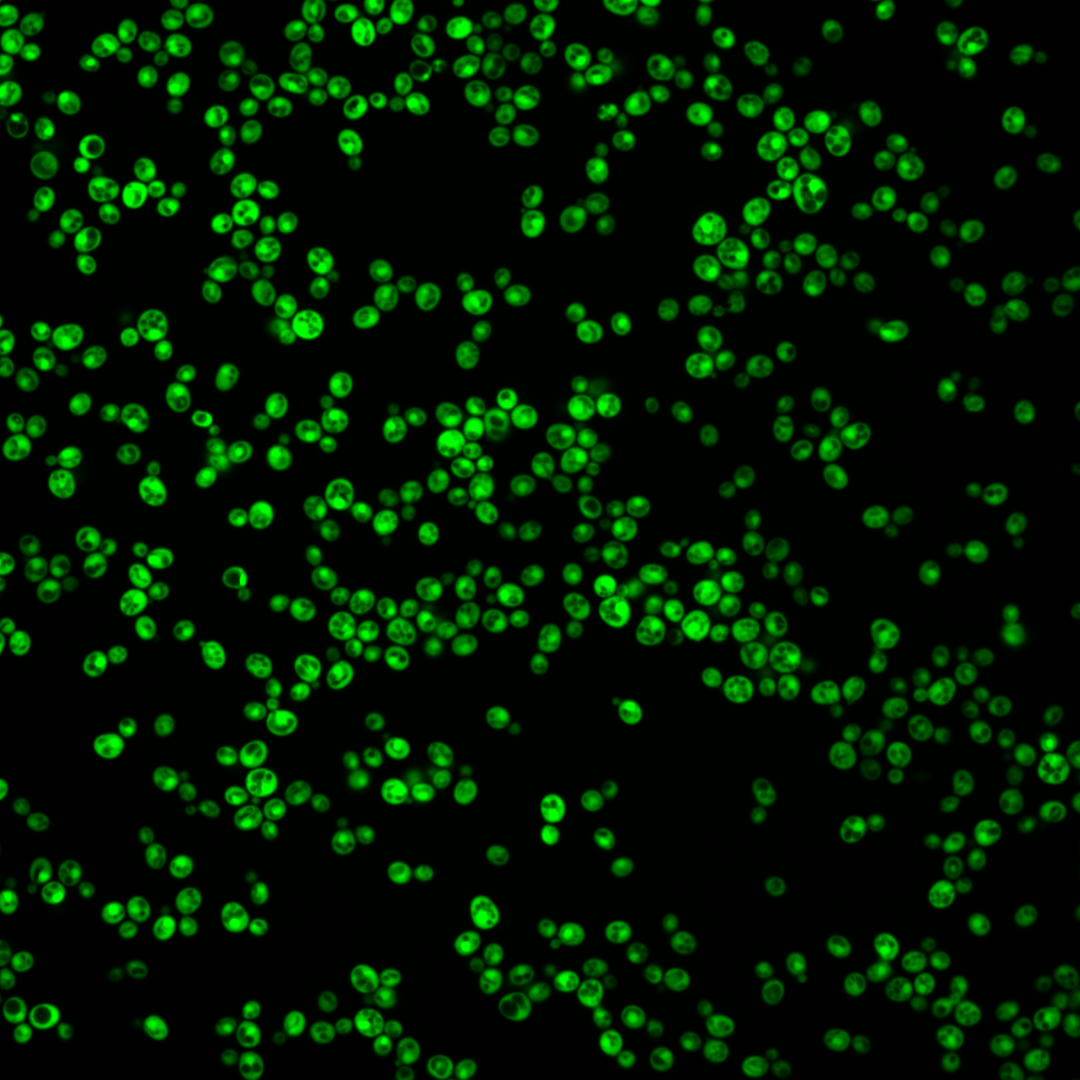
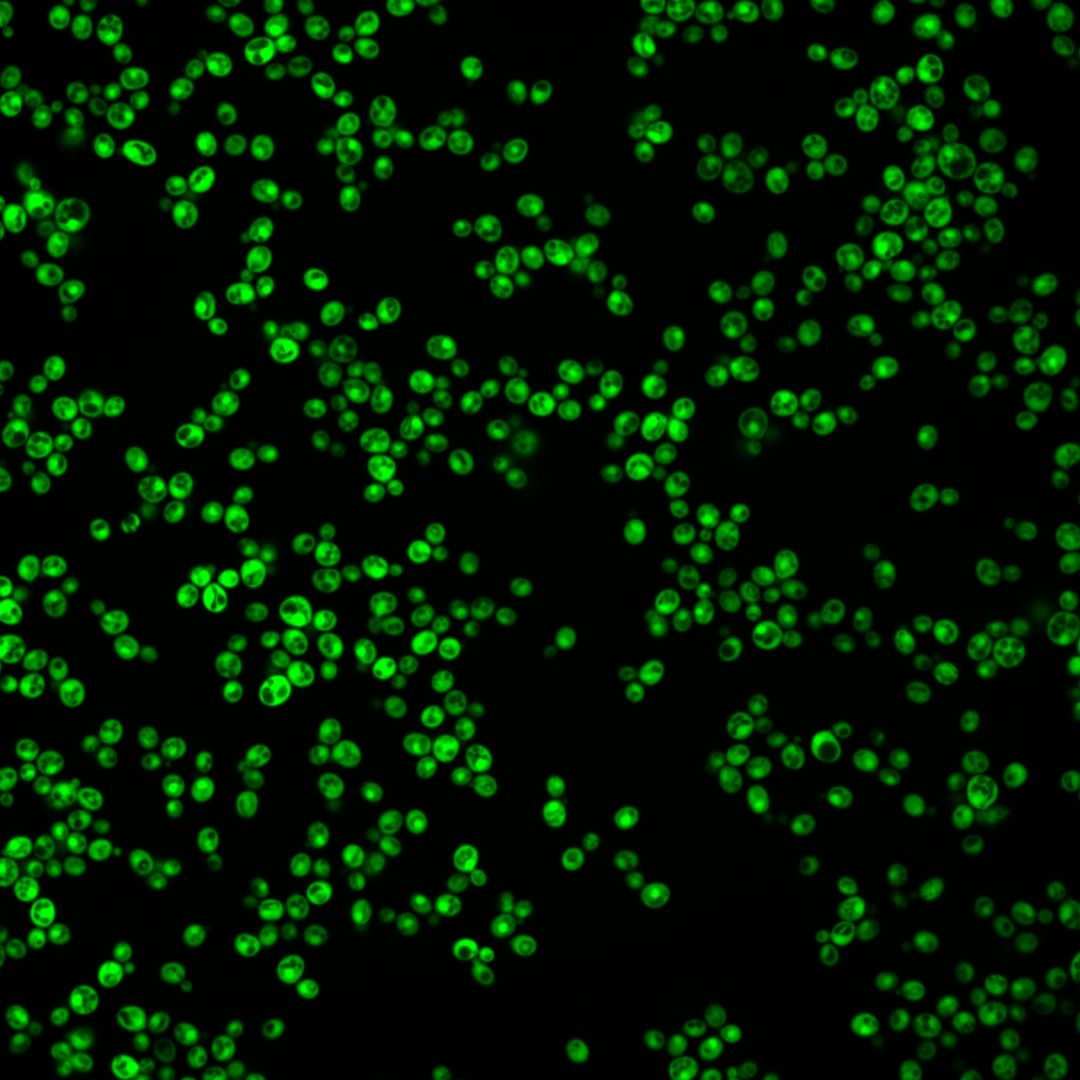
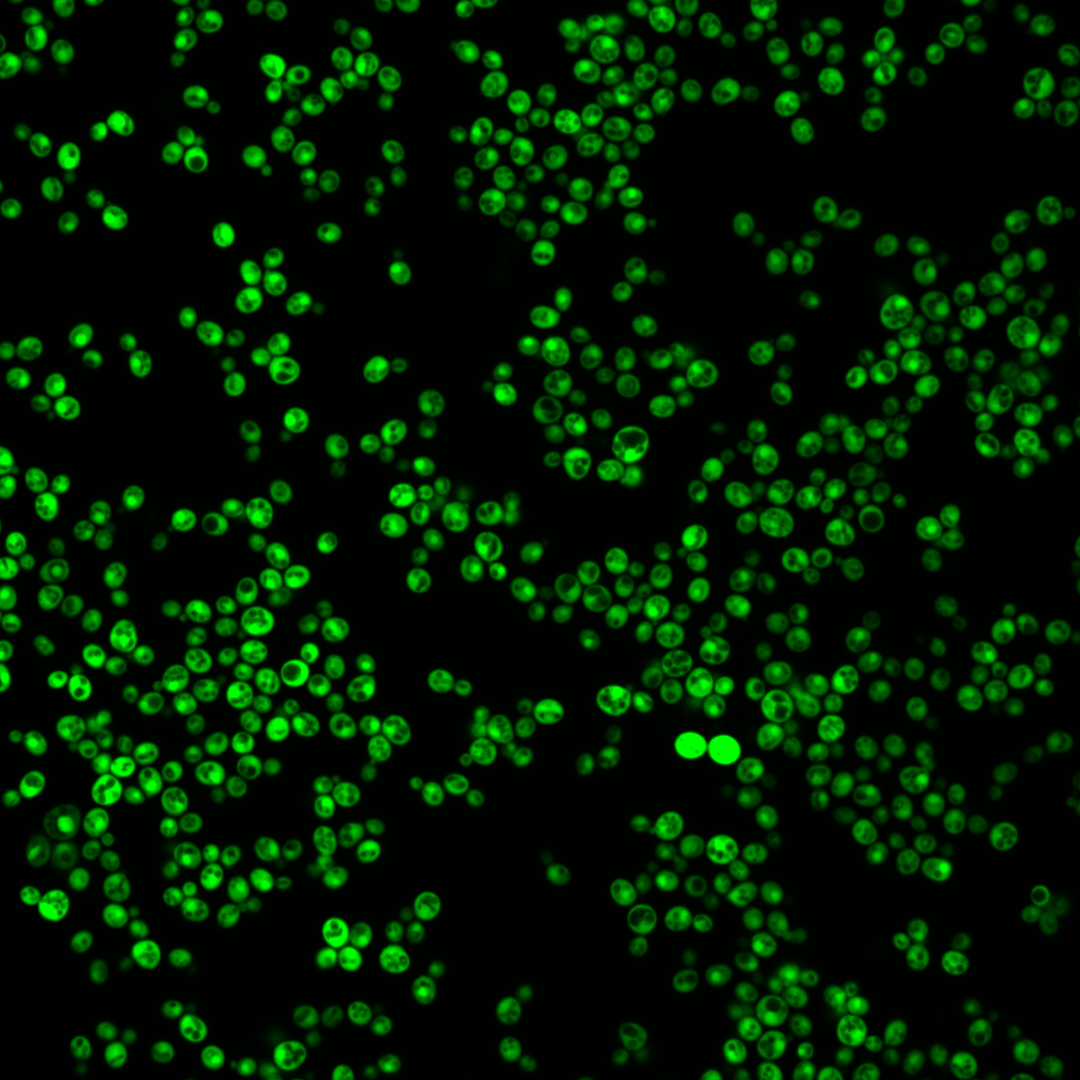
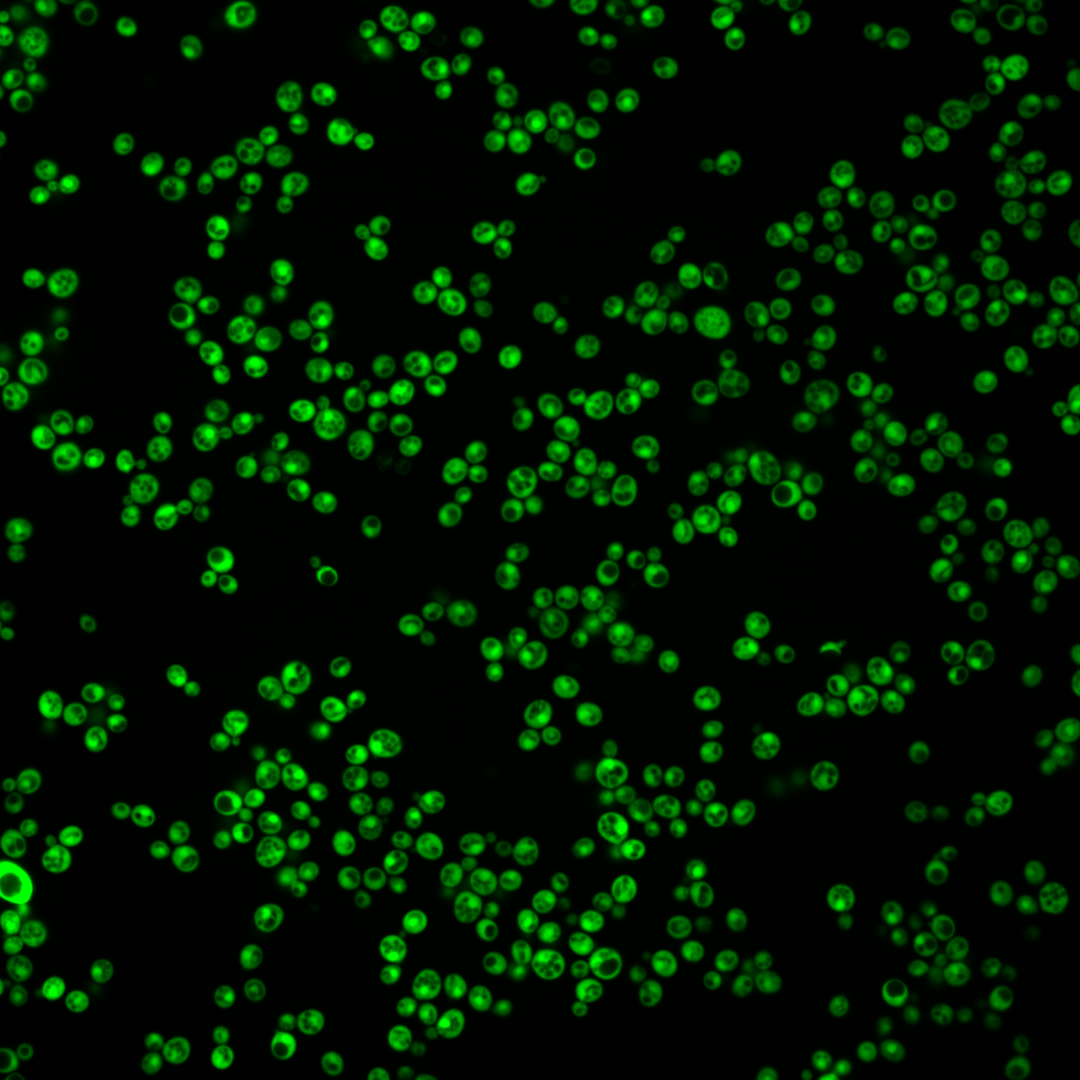
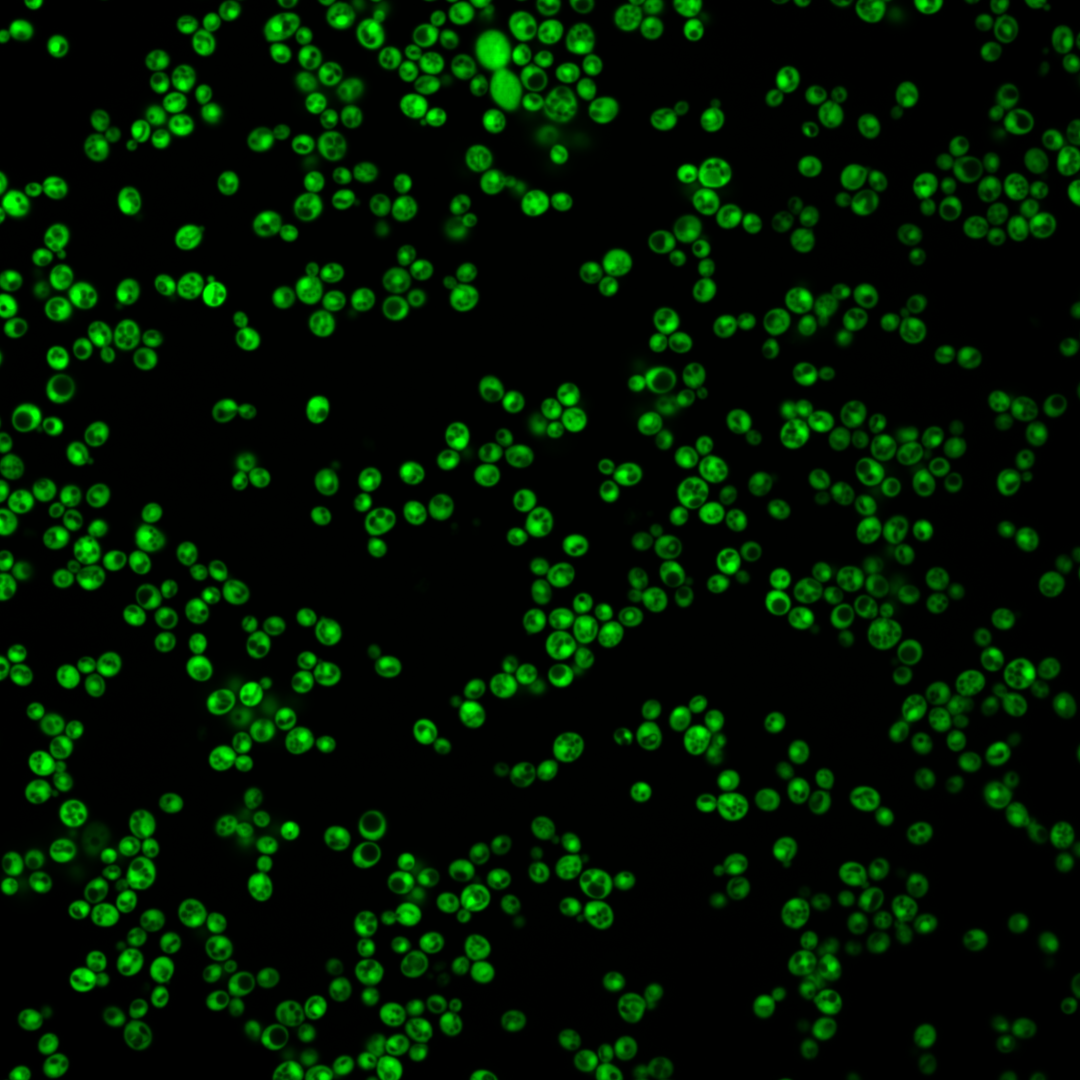
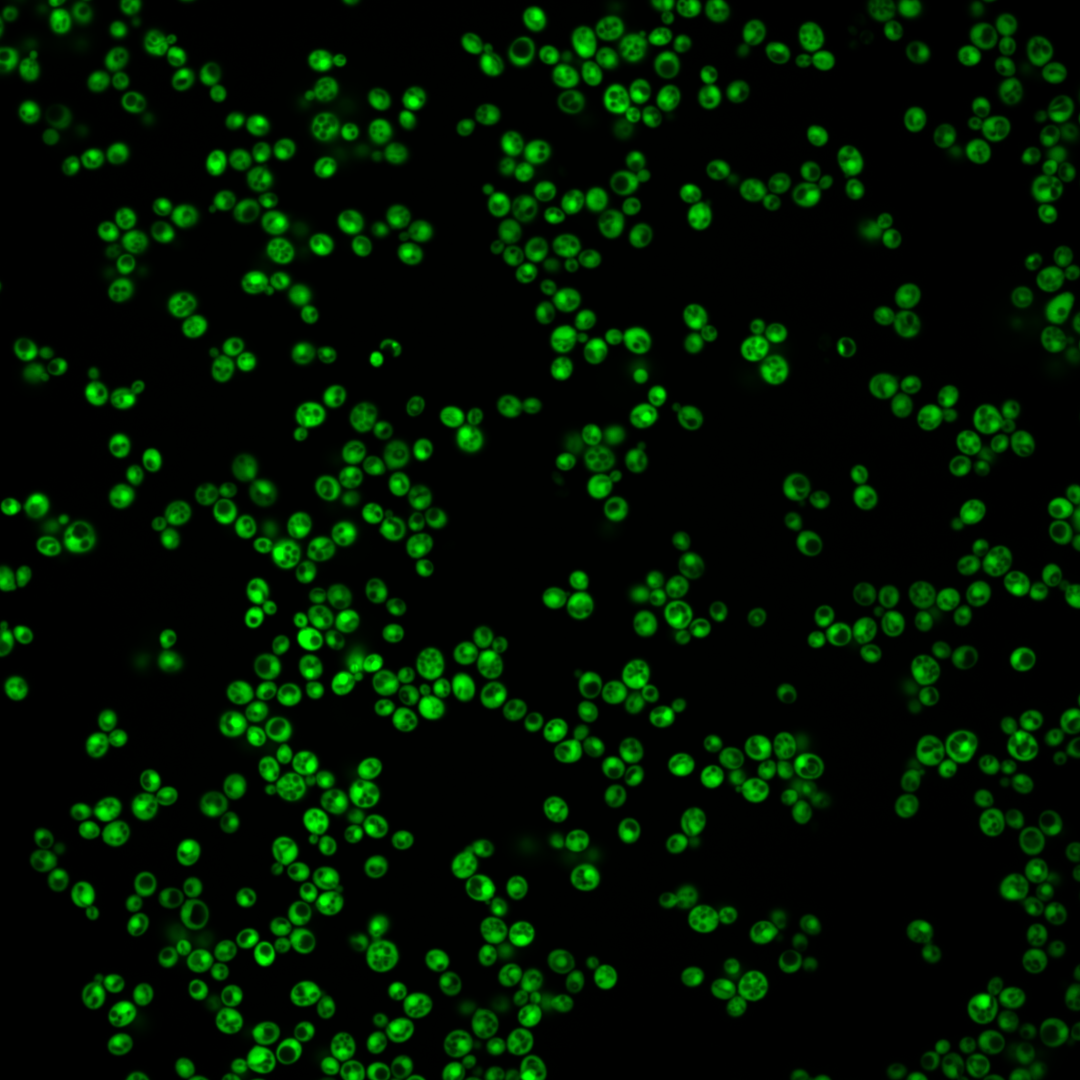

| Standard name | |
|---|---|
| Human Ortholog | |
| Description | Glyceraldehyde-3-phosphate dehydrogenase (GAPDH), isozyme 2; involved in glycolysis and gluconeogenesis; tetramer that catalyzes reaction of glyceraldehyde-3-phosphate to 1,3 bis-phosphoglycerate; detected in cytoplasm and cell wall; protein abundance increases in response to DNA replication stress; GAPDH-derived antimicrobial peptides are active against a wide variety of wine-related yeasts and bateria; TDH2 has a paralog, TDH3, that arose from the whole genome duplication |
Micrographs




















































































Sub-cellular Localization
Yeast GFP Assignment
Protein Abundance
Localization Change
External localization resources
| ensLOC | DeepLoc | |||||||||||||||||||||||
|---|---|---|---|---|---|---|---|---|---|---|---|---|---|---|---|---|---|---|---|---|---|---|---|---|
| Localization | WT1 | WT2 | WT3 | RAP60 | RAP140 | RAP220 | RAP300 | RAP380 | RAP460 | RAP540 | RAP620 | RAP700 | HU80 | HU120 | HU160 | rpd3Δ_1 | rpd3Δ_2 | rpd3Δ_3 | WT1 | WT2 | WT3 | AF100 | AF140 | AF180 |
| Cortical Patches | 0 | 0 | 0 | 0 | 0 | 0 | 0 | 0 | 0 | 0 | 0 | 0 | 0 | 0 | 0 | 0 | 0 | 0 | 0 | 0 | 0 | 1 | 0 | 0 |
| Bud | 0 | 0 | 0 | 1 | 3 | 0 | 1 | 4 | 4 | 2 | 2 | 4 | 0 | 4 | 0 | 1 | 1 | 1 | 0 | 1 | 0 | 3 | 3 | 3 |
| Bud Neck | 0 | 0 | 0 | 0 | 0 | 0 | 0 | 0 | 0 | 0 | 0 | 0 | 0 | 0 | 0 | 0 | 0 | 0 | 0 | 0 | 0 | 0 | 0 | 0 |
| Bud Site | 0 | 0 | 0 | 0 | 0 | 0 | 0 | 0 | 0 | 0 | 0 | 0 | 0 | 0 | 0 | 0 | 0 | 0 | – | – | – | – | – | – |
| Cell Periphery | 0 | 1 | 2 | 5 | 2 | 0 | 4 | 4 | 8 | 6 | 1 | 7 | 141 | 251 | 296 | 4 | 2 | 6 | 0 | 0 | 0 | 10 | 52 | 54 |
| Cytoplasm | 195 | 88 | 128 | 188 | 314 | 309 | 357 | 321 | 293 | 275 | 255 | 237 | 222 | 267 | 198 | 326 | 87 | 271 | 155 | 96 | 122 | 442 | 586 | 593 |
| Endoplasmic Reticulum | 0 | 0 | 0 | 0 | 1 | 2 | 17 | 25 | 10 | 19 | 9 | 10 | 0 | 0 | 0 | 16 | 6 | 13 | 3 | 3 | 0 | 13 | 12 | 15 |
| Endosome | 0 | 0 | 0 | 0 | 0 | 0 | 0 | 0 | 0 | 0 | 0 | 0 | 0 | 0 | 0 | 0 | 0 | 0 | 0 | 0 | 0 | 0 | 0 | 0 |
| Golgi | 0 | 0 | 0 | 0 | 1 | 0 | 0 | 0 | 0 | 0 | 0 | 1 | 0 | 0 | 2 | 0 | 0 | 4 | 0 | 0 | 0 | 0 | 0 | 0 |
| Mitochondria | 0 | 0 | 0 | 0 | 0 | 0 | 0 | 0 | 0 | 0 | 0 | 0 | 0 | 0 | 0 | 0 | 0 | 0 | 0 | 0 | 0 | 0 | 0 | 0 |
| Nucleus | 0 | 1 | 0 | 0 | 0 | 0 | 0 | 0 | 0 | 0 | 1 | 0 | 0 | 0 | 0 | 0 | 0 | 0 | 1 | 7 | 1 | 1 | 1 | 0 |
| Nuclear Periphery | 0 | 1 | 0 | 0 | 0 | 0 | 0 | 0 | 0 | 0 | 0 | 1 | 0 | 0 | 0 | 0 | 0 | 0 | 0 | 0 | 0 | 3 | 2 | 1 |
| Nucleolus | 0 | 0 | 0 | 0 | 0 | 0 | 0 | 8 | 2 | 4 | 1 | 3 | 0 | 0 | 0 | 0 | 0 | 0 | 0 | 0 | 0 | 0 | 0 | 0 |
| Peroxisomes | 0 | 0 | 0 | 0 | 0 | 0 | 0 | 0 | 0 | 0 | 0 | 0 | 0 | 0 | 0 | 0 | 0 | 0 | 0 | 0 | 0 | 0 | 0 | 0 |
| SpindlePole | 0 | 0 | 0 | 0 | 0 | 0 | 0 | 0 | 0 | 0 | 0 | 0 | 0 | 0 | 0 | 0 | 0 | 0 | 0 | 0 | 0 | 0 | 0 | 0 |
| Vac/Vac Membrane | 0 | 0 | 0 | 0 | 1 | 1 | 1 | 0 | 1 | 1 | 0 | 1 | 0 | 0 | 1 | 2 | 1 | 2 | 0 | 1 | 0 | 2 | 1 | 1 |
| Unique Cell Count | 195 | 90 | 129 | 191 | 319 | 311 | 378 | 360 | 313 | 304 | 268 | 261 | 320 | 456 | 436 | 332 | 90 | 280 | 166 | 113 | 131 | 490 | 674 | 681 |
| Labelled Cell Count | 195 | 91 | 130 | 194 | 322 | 312 | 380 | 362 | 318 | 307 | 269 | 264 | 363 | 522 | 497 | 349 | 97 | 297 | 166 | 113 | 131 | 490 | 674 | 681 |
Yeast GFP Assignment
Protein Abundance
| Screen | WT1 | WT2 | WT3 | RAP60 | RAP140 | RAP220 | RAP300 | RAP380 | RAP460 | RAP540 | RAP620 | RAP700 | HU80 | HU120 | HU160 | rpd3Δ_1 | rpd3Δ_2 | rpd3Δ_3 | AF100 | AF140 | AF180 |
|---|---|---|---|---|---|---|---|---|---|---|---|---|---|---|---|---|---|---|---|---|---|
| Mean Cell GFP Intensity (1e-4) | 402.6 | 368.1 | 369.9 | 376.3 | 336.6 | 273.0 | 240.2 | 220.6 | 214.5 | 205.9 | 192.4 | 192.5 | 595.0 | 641.9 | 646.8 | 290.8 | 333.4 | 322.3 | 523.2 | 577.4 | 584.9 |
| Std Deviation (1e-4) | 76.0 | 114.7 | 93.3 | 82.0 | 76.8 | 66.1 | 59.1 | 54.5 | 56.4 | 51.8 | 50.6 | 49.7 | 116.1 | 123.8 | 130.6 | 103.8 | 119.1 | 114.3 | 115.3 | 118.1 | 130.1 |
| Intensity Change (Log2) | – | – | – | 0.02 | -0.14 | -0.44 | -0.62 | -0.75 | -0.79 | -0.85 | -0.94 | -0.94 | 0.69 | 0.8 | 0.81 | -0.35 | -0.15 | -0.2 | 0.5 | 0.64 | 0.66 |
Localization Change
| Localization | RAP60 | RAP140 | RAP220 | RAP300 | RAP380 | RAP460 | RAP540 | RAP620 | RAP700 | HU80 | HU120 | HU160 | rpd3Δ_1 | rpd3Δ_2 | rpd3Δ_3 |
|---|---|---|---|---|---|---|---|---|---|---|---|---|---|---|---|
| Cortical Patches | 0 | 0 | 0 | 0 | 0 | 0 | 0 | 0 | 0 | 0 | 0 | 0 | 0 | 0 | 0 |
| Bud | 0 | 0 | 0 | 0 | 0 | 0 | 0 | 0 | 0 | 0 | 0 | 0 | 0 | 0 | 0 |
| Bud Neck | 0 | 0 | 0 | 0 | 0 | 0 | 0 | 0 | 0 | 0 | 0 | 0 | 0 | 0 | 0 |
| Bud Site | 0 | 0 | 0 | 0 | 0 | 0 | 0 | 0 | 0 | 0 | 0 | 0 | 0 | 0 | 0 |
| Cell Periphery | 0 | 0 | 0 | 0 | 0 | 0 | 0 | 0 | 0 | 8.7 | 10.8 | 13.3 | 0 | 0 | 0 |
| Cytoplasm | -0.6 | -0.7 | 0.2 | -2.3 | -3.6 | -2.5 | -3.3 | -2.1 | -3.2 | -6.9 | -8.7 | -10.9 | -0.8 | -1.4 | -1.5 |
| Endoplasmic Reticulum | 0 | 0 | 0 | 0 | 3.1 | 0 | 2.9 | 0 | 0 | 0 | 0 | 0 | 0 | 0 | 0 |
| Endosome | 0 | 0 | 0 | 0 | 0 | 0 | 0 | 0 | 0 | 0 | 0 | 0 | 0 | 0 | 0 |
| Golgi | 0 | 0 | 0 | 0 | 0 | 0 | 0 | 0 | 0 | 0 | 0 | 0 | 0 | 0 | 0 |
| Mitochondria | 0 | 0 | 0 | 0 | 0 | 0 | 0 | 0 | 0 | 0 | 0 | 0 | 0 | 0 | 0 |
| Nucleus | 0 | 0 | 0 | 0 | 0 | 0 | 0 | 0 | 0 | 0 | 0 | 0 | 0 | 0 | 0 |
| Nuclear Periphery | 0 | 0 | 0 | 0 | 0 | 0 | 0 | 0 | 0 | 0 | 0 | 0 | 0 | 0 | 0 |
| Nucleolus | 0 | 0 | 0 | 0 | 0 | 0 | 0 | 0 | 0 | 0 | 0 | 0 | 0 | 0 | 0 |
| Peroxisomes | 0 | 0 | 0 | 0 | 0 | 0 | 0 | 0 | 0 | 0 | 0 | 0 | 0 | 0 | 0 |
| SpindlePole | 0 | 0 | 0 | 0 | 0 | 0 | 0 | 0 | 0 | 0 | 0 | 0 | 0 | 0 | 0 |
| Vacuole | 0 | 0 | 0 | 0 | 0 | 0 | 0 | 0 | 0 | 0 | 0 | 0 | 0 | 0 | 0 |
External localization resources
Images






























Protein Concentration and Protein Localization Data
| R1 | R2 | R3 | ||||||||||||||||
|---|---|---|---|---|---|---|---|---|---|---|---|---|---|---|---|---|---|---|
| G1 Pre-START | G1 Post-START | S/G2 | Metaphase | Anaphase | Telophase | G1 Pre-START | G1 Post-START | S/G2 | Metaphase | Anaphase | Telophase | G1 Pre-START | G1 Post-START | S/G2 | Metaphase | Anaphase | Telophase | |
| Concentration | 295.0947 | 361.1866 | 311.6672 | 313.0977 | 255.0932 | 336.1491 | 294.1918 | 393.9647 | 372.127 | 368.2975 | 311.0985 | 375.154 | 289.7679 | 342.9718 | 305.4889 | 299.6234 | 263.6177 | 390.9119 |
| Actin | 0.0038 | 0.0002 | 0.0008 | 0.0025 | 0.0161 | 0.0002 | 0.0028 | 0.0002 | 0.0032 | 0.0173 | 0.0069 | 0.0006 | 0.0074 | 0.0003 | 0.0002 | 0.0006 | 0.0008 | 0.0857 |
| Bud | 0.0011 | 0.0005 | 0.0055 | 0.0002 | 0.0002 | 0.0002 | 0.0035 | 0.0002 | 0.0014 | 0.0004 | 0.0003 | 0.0002 | 0.0005 | 0.0005 | 0.0001 | 0.0008 | 0.0008 | 0.0007 |
| Bud Neck | 0.0004 | 0.0002 | 0.0002 | 0.0005 | 0.0003 | 0.0003 | 0.0006 | 0.0001 | 0.0002 | 0.0035 | 0.0003 | 0.0004 | 0.0007 | 0.0002 | 0.0001 | 0.0002 | 0.0003 | 0.0009 |
| Bud Periphery | 0.0006 | 0.0001 | 0.0019 | 0.0001 | 0.0001 | 0.0001 | 0.0015 | 0 | 0.0008 | 0.0009 | 0.0002 | 0.0001 | 0.0002 | 0.0001 | 0 | 0.0004 | 0.0001 | 0.0004 |
| Bud Site | 0.0002 | 0.0002 | 0.0006 | 0.0001 | 0.0003 | 0.0003 | 0.0021 | 0.0001 | 0.0011 | 0.001 | 0.0004 | 0.0001 | 0.0003 | 0.0001 | 0.0001 | 0.0003 | 0.0007 | 0.0002 |
| Cell Periphery | 0.0006 | 0.0008 | 0.0011 | 0.0001 | 0.0009 | 0.0001 | 0.0014 | 0.0001 | 0.0006 | 0.0034 | 0.0004 | 0 | 0.0004 | 0.0009 | 0.0001 | 0.0012 | 0.0007 | 0.0001 |
| Cytoplasm | 0.4565 | 0.7702 | 0.6105 | 0.5991 | 0.5692 | 0.6232 | 0.4417 | 0.7678 | 0.6401 | 0.5042 | 0.6625 | 0.4318 | 0.4037 | 0.7854 | 0.6077 | 0.5358 | 0.463 | 0.5157 |
| Cytoplasmic Foci | 0.0061 | 0.0011 | 0.0035 | 0.0014 | 0.0383 | 0.0106 | 0.0115 | 0.0031 | 0.0112 | 0.0003 | 0.0109 | 0.006 | 0.0083 | 0.0002 | 0.0059 | 0.0003 | 0.0533 | 0.002 |
| Eisosomes | 0.0002 | 0.0001 | 0.0002 | 0 | 0.0014 | 0.0001 | 0.0005 | 0 | 0.0002 | 0.0001 | 0.0001 | 0 | 0.001 | 0.0001 | 0.0001 | 0.0003 | 0.0037 | 0.0005 |
| Endoplasmic Reticulum | 0.002 | 0.0001 | 0.0014 | 0.0153 | 0.003 | 0.0009 | 0.0015 | 0.0001 | 0.0002 | 0.0007 | 0.0011 | 0.0001 | 0.0023 | 0.0001 | 0.0002 | 0.0001 | 0.0002 | 0.0014 |
| Endosome | 0.0017 | 0 | 0.0024 | 0.0098 | 0.0078 | 0.0089 | 0.0075 | 0 | 0.0013 | 0.0002 | 0.0488 | 0.0023 | 0.0045 | 0 | 0.0004 | 0.0001 | 0.0002 | 0.0074 |
| Golgi | 0.0002 | 0 | 0.0001 | 0.0007 | 0.0078 | 0.0002 | 0.0016 | 0 | 0.0015 | 0.0004 | 0.0077 | 0.0014 | 0.0008 | 0 | 0.0001 | 0 | 0.0005 | 0.0063 |
| Lipid Particles | 0.0006 | 0.0001 | 0.0007 | 0.0002 | 0.0148 | 0.0007 | 0.0046 | 0.0001 | 0.0027 | 0.0001 | 0.0214 | 0.0181 | 0.0015 | 0 | 0.0014 | 0.0001 | 0.0168 | 0.0058 |
| Mitochondria | 0.0057 | 0.0025 | 0.0031 | 0.0008 | 0.0031 | 0.0038 | 0.0155 | 0.0015 | 0.0127 | 0.0007 | 0.0093 | 0.0009 | 0.0052 | 0.009 | 0.0046 | 0.0078 | 0.0183 | 0.0023 |
| None | 0.0048 | 0.0018 | 0.0113 | 0.0006 | 0.0629 | 0.0186 | 0.013 | 0.0013 | 0.0111 | 0.0012 | 0.0148 | 0.0004 | 0.0035 | 0.001 | 0.0022 | 0.002 | 0.0132 | 0.0026 |
| Nuclear Periphery | 0.0353 | 0.0125 | 0.0374 | 0.0275 | 0.0151 | 0.0245 | 0.02 | 0.0109 | 0.0125 | 0.0257 | 0.0138 | 0.0198 | 0.0279 | 0.0119 | 0.015 | 0.0235 | 0.0382 | 0.0172 |
| Nucleolus | 0.0162 | 0.0059 | 0.0063 | 0.0009 | 0.0527 | 0.0025 | 0.0365 | 0.0044 | 0.0233 | 0.003 | 0.0049 | 0.0011 | 0.004 | 0.0029 | 0.0109 | 0.0237 | 0.0636 | 0.0003 |
| Nucleus | 0.4583 | 0.2014 | 0.2953 | 0.3371 | 0.1923 | 0.2934 | 0.4203 | 0.2088 | 0.266 | 0.4348 | 0.1454 | 0.4953 | 0.5231 | 0.1853 | 0.3462 | 0.3986 | 0.3103 | 0.3432 |
| Peroxisomes | 0.0002 | 0.0001 | 0.0001 | 0.0001 | 0.0068 | 0.0003 | 0.0033 | 0.0001 | 0.0049 | 0 | 0.0418 | 0.0105 | 0.0003 | 0 | 0.0002 | 0.0002 | 0.0031 | 0.0033 |
| Punctate Nuclear | 0.0016 | 0.0004 | 0.0108 | 0.0011 | 0.0041 | 0.0013 | 0.0033 | 0.0005 | 0.0015 | 0.0006 | 0.0006 | 0.0098 | 0.0012 | 0.0004 | 0.0034 | 0.0013 | 0.0077 | 0.0028 |
| Vacuole | 0.0022 | 0.0012 | 0.0046 | 0.0012 | 0.0017 | 0.0072 | 0.0043 | 0.0005 | 0.0021 | 0.0009 | 0.0044 | 0.0005 | 0.0017 | 0.001 | 0.0004 | 0.0013 | 0.0016 | 0.0005 |
| Vacuole Periphery | 0.0018 | 0.0005 | 0.0021 | 0.0007 | 0.0012 | 0.0026 | 0.0027 | 0.0004 | 0.0012 | 0.0005 | 0.004 | 0.0005 | 0.0014 | 0.0006 | 0.0005 | 0.0017 | 0.0029 | 0.0007 |
Sequencing Data
| R1 | R2 | |||||||||
|---|---|---|---|---|---|---|---|---|---|---|
| G1 Post-START | S/G2 | Metaphase | Anaphase | Telophase | G1 Post-START | S/G2 | Metaphase | Anaphase | Telophase | |
| Gene Expression | 10299.546 | 11083.1557 | 12563.7625 | 9055.2188 | 11109.0824 | 10906.5072 | 11313.9861 | 11253.8116 | 13554.1656 | 9818.8314 |
| Translational Efficiency | 0.7189 | 0.7239 | 0.6685 | 0.8599 | 0.7131 | 0.7196 | 0.9364 | 0.931 | 0.7741 | 0.972 |
Hit Data
| Dataset | Hit |
|---|---|
| Protein Concentration | ✘ |
| Protein Localization | ✘ |
| Gene Expression | ✘ |
| Translational Efficiency | ✘ |
Micrographs
































Cell Count
| R1 | R2 | R1 & R2 | |||||||||
|---|---|---|---|---|---|---|---|---|---|---|---|
| WT | UBP2 | UBP14 | UBP2UBP14 | WT | UBP2 | UBP14 | UBP2UBP14 | WT | UBP2 | UBP14 | UBP2UBP14 |
| 1462 | 406 | 2218 | 291 | 1514 | 1992 | 1592 | 1267 | 2976 | 2398 | 3810 | 1558 |
Protein Abundance
| R1 | R2 | R1 & R2 | ||||||||||
|---|---|---|---|---|---|---|---|---|---|---|---|---|
| WT | UBP2 | UBP14 | UBP2UBP14 | WT | UBP2 | UBP14 | UBP2UBP14 | WT | UBP2 | UBP14 | UBP2UBP14 | |
| Mean | 24380.07 | 20769.40 | 43105.50 | 44977.70 | 21707.46 | 24756.18 | 44145.61 | 38220.48 | 23020.42 | 24081.19 | 43540.11 | 39482.58 |
| Standard Deviation | 6702.84 | 7232.81 | 8621.78 | 8964.52 | 5809.69 | 7095.07 | 7822.57 | 10819.82 | 6405.29 | 7273.90 | 8313.04 | 10823.49 |
| Intensity Change Log 2 | — | -0.231243 | 0.822170 | 0.883508 | — | 0.189598 | 1.024079 | 0.816155 | — | -0.017699 | 0.920797 | 0.852176 |
Localization Score (DeepLoc)
| R1 | R2 | R1 & R2 | ||||||||||
|---|---|---|---|---|---|---|---|---|---|---|---|---|
| WT | UBP2 | UBP14 | UBP2UBP14 | WT | UBP2 | UBP14 | UBP2UBP14 | WT | UBP2 | UBP14 | UBP2UBP14 | |
| Actin | 0.000051 | 0.000092 | 0.000107 | 0.000137 | 0.000062 | 0.000051 | 0.000152 | 0.000145 | 0.000057 | 0.000058 | 0.000126 | 0.000143 |
| Bud Neck | 0.000561 | 0.001221 | 0.000384 | 0.001276 | 0.000849 | 0.000740 | 0.001256 | 0.000749 | 0.000707 | 0.000821 | 0.000748 | 0.000848 |
| Bud Site | 0.000178 | 0.000442 | 0.000674 | 0.002607 | 0.000217 | 0.000229 | 0.000807 | 0.002654 | 0.000198 | 0.000265 | 0.000729 | 0.002645 |
| Cell Periphery | 0.000840 | 0.000994 | 0.063294 | 0.137252* | 0.000280 | 0.000303 | 0.069615 | 0.068963 | 0.000555 | 0.000420 | 0.065935 | 0.081718 |
| Cytoplasm | 0.305960* | 0.215954* | 0.502473* | 0.331559* | 0.216730* | 0.270268* | 0.324175* | 0.494421* | 0.260566* | 0.261073* | 0.427971* | 0.464002* |
| Cytoplasmic Foci | 0.001766 | 0.004983 | 0.000117 | 0.001232 | 0.002419 | 0.000958 | 0.000175 | 0.002978 | 0.002099 | 0.001639 | 0.000141 | 0.002652 |
| Eisosomes | 0.000001 | 0.000003 | 0.000004 | 0.000016 | 0.000002 | 0.000001 | 0.000014 | 0.000012 | 0.000001 | 0.000001 | 0.000008 | 0.000013 |
| Endoplasmic Reticulum | 0.000049 | 0.000081 | 0.000124 | 0.000011 | 0.000039 | 0.000085 | 0.000130 | 0.000030 | 0.000044 | 0.000084 | 0.000127 | 0.000027 |
| Endosome | 0.000008 | 0.000023 | 0.000020 | 0.000011 | 0.000009 | 0.000011 | 0.000064 | 0.000015 | 0.000008 | 0.000013 | 0.000038 | 0.000015 |
| Golgi | 0.000164 | 0.000270 | 0.000079 | 0.000144 | 0.000122 | 0.000056 | 0.000163 | 0.000159 | 0.000143 | 0.000092 | 0.000114 | 0.000156 |
| Lipid Particles | 0.000319 | 0.000229 | 0.001314 | 0.005055 | 0.000064 | 0.000046 | 0.005578 | 0.002603 | 0.000189 | 0.000077 | 0.003096 | 0.003061 |
| Mitochondria | 0.000374 | 0.000458 | 0.000100 | 0.000031 | 0.000451 | 0.000367 | 0.000091 | 0.000110 | 0.000413 | 0.000382 | 0.000096 | 0.000095 |
| Mitotic Spindle | 0.000055 | 0.002208 | 0.000005 | 0.000014 | 0.000077 | 0.000123 | 0.000008 | 0.000036 | 0.000066 | 0.000476 | 0.000006 | 0.000032 |
| None | 0.004791 | 0.005938 | 0.000876 | 0.000734 | 0.006771 | 0.009371 | 0.000276 | 0.004257 | 0.005799 | 0.008790 | 0.000625 | 0.003599 |
| Nuclear Periphery | 0.000238 | 0.000237 | 0.000097 | 0.000280 | 0.000259 | 0.000228 | 0.000226 | 0.000168 | 0.000248 | 0.000230 | 0.000151 | 0.000189 |
| Nuclear Periphery Foci | 0.000308 | 0.000304 | 0.000262 | 0.000737 | 0.000197 | 0.000106 | 0.000667 | 0.000546 | 0.000252 | 0.000140 | 0.000431 | 0.000582 |
| Nucleolus | 0.000034 | 0.000106 | 0.000061 | 0.000065 | 0.000079 | 0.000056 | 0.000076 | 0.000085 | 0.000057 | 0.000064 | 0.000068 | 0.000082 |
| Nucleus | 0.681321* | 0.764292* | 0.032801 | 0.025525 | 0.770173* | 0.714298* | 0.016732 | 0.047939 | 0.726523* | 0.722762* | 0.026086 | 0.043752 |
| Peroxisomes | 0.000001 | 0.000090 | 0.000020 | 0.000009 | 0.000005 | 0.000002 | 0.000011 | 0.000015 | 0.000003 | 0.000017 | 0.000016 | 0.000014 |
| Vacuole | 0.002530 | 0.001957 | 0.396557* | 0.492243* | 0.000842 | 0.002571 | 0.578366* | 0.373406* | 0.001671 | 0.002467 | 0.472526* | 0.395602* |
| Vacuole Periphery | 0.000447 | 0.000117 | 0.000634 | 0.001062 | 0.000353 | 0.000131 | 0.001418 | 0.000708 | 0.000399 | 0.000128 | 0.000961 | 0.000774 |
Localization Changes (T-score)
| R1 | R2 | R1 & R2 | |||||||||||||
|---|---|---|---|---|---|---|---|---|---|---|---|---|---|---|---|
| UBP2_WT | UBP14_WT | UBP2UBP14_WT | UBP2UBP14_UBP2 | UBP2UBP14_UBP14 | UBP2_WT | UBP14_WT | UBP2UBP14_WT | UBP2UBP14_UBP2 | UBP2UBP14_UBP14 | UBP2_WT | UBP14_WT | UBP2UBP14_WT | UBP2UBP14_UBP2 | UBP2UBP14_UBP14 | |
| Actin | -2.56 | -9.43 | -3.87 | -1.67 | -1.33 | 1.65 | -9.02 | -6.71 | -8.03 | 1.29 | -0.47 | -12.47 | -8.34 | -7.95 | -1.10 |
| Bud Neck | -4.79 | 1.68 | -5.12 | -0.18 | -6.61 | -0.39 | -6.83 | -0.91 | -0.47 | 6.54 | -3.15 | -3.49 | -4.09 | -0.63 | -0.37 |
| Bud Site | -3.01 | -6.22 | -3.72 | -3.07 | -2.99 | -0.89 | -3.24 | -3.36 | -3.30 | -1.91 | -2.70 | -5.39 | -4.16 | -3.94 | -2.93 |
| Cell Periphery | -0.35 | -26.17* | -12.57 | -12.54 | -5.75 | -0.25 | -27.64* | -19.25 | -19.24 | 1.24 | 1.01 | -37.34 | -22.49 | -22.55 | -1.93 |
| Cytoplasm | 7.64 | -22.23 | -4.55 | -8.89 | 6.81 | -6.25 | -16.52 | -31.78 | -26.84 | -15.82 | 1.06 | -28.85 | -27.65 | -27.59 | -5.98 |
| Cytoplasmic Foci | -3.70 | 7.74 | -1.60 | 2.19 | -4.37 | 3.87 | 6.23 | -1.05 | -2.88 | -3.90 | 1.25 | 9.52 | -1.66 | -2.18 | -4.77 |
| Eisosomes | -3.85 | -7.22 | -8.08 | -6.25 | -6.78 | 2.45 | -9.66 | -4.63 | -4.91 | 1.47 | -0.12 | -11.29 | -6.17 | -6.16 | -2.07 |
| Endoplasmic Reticulum | -1.10 | -5.53 | 4.91 | 2.44 | 10.35 | -3.26 | -5.11 | 2.43 | 4.05 | 5.74 | -3.09 | -7.80 | 3.75 | 4.71 | 9.93 |
| Endosome | -1.36 | -6.65 | -1.97 | 0.71 | 1.37 | -2.23 | -2.39 | -3.93 | -1.60 | 2.07 | -2.65 | -3.04 | -4.76 | -0.51 | 2.26 |
| Golgi | -0.46 | 1.83 | -0.55 | 0.28 | -3.75 | 1.87 | -1.39 | -0.74 | -4.09 | 0.82 | 1.52 | 0.68 | -0.61 | -2.44 | -1.89 |
| Lipid Particles | 0.46 | -4.75 | -7.11 | -7.33 | -5.71 | 0.82 | -16.64 | -10.21 | -10.40 | 6.51 | 1.44 | -15.67 | -11.53 | -12.66 | -0.67 |
| Mitochondria | -2.32 | 11.96 | 14.76 | 8.06 | 6.30 | 2.02 | 7.95 | 8.56 | 8.15 | -0.25 | 0.24 | 13.02 | 10.93 | 10.50 | 0.46 |
| Mitotic Spindle | -1.46 | 2.22 | 1.78 | 1.48 | -4.18 | -2.36 | 3.08 | 1.76 | 3.24 | -2.57 | -1.92 | 3.80 | 1.93 | 2.04 | -2.83 |
| None | -1.41 | 12.84 | 9.15 | 5.60 | 0.06 | -2.15 | 9.27 | 2.39 | 3.95 | -3.17 | -3.46 | 13.26 | 2.72 | 4.76 | -2.85 |
| Nuclear Periphery | -0.90 | 2.96 | -1.57 | -0.70 | -7.12 | 0.20 | 0.61 | 1.81 | 3.72 | 4.92 | -0.25 | 2.62 | 1.53 | 3.07 | -3.77 |
| Nuclear Periphery Foci | 0.50 | 0.66 | -2.71 | -3.24 | -5.83 | 1.42 | -5.01 | -4.02 | -10.04 | 1.33 | 1.91 | -1.68 | -3.65 | -10.06 | -4.00 |
| Nucleolus | -1.76 | -4.54 | -4.24 | 0.91 | -1.23 | 0.53 | 0.10 | 0.25 | -0.72 | 0.64 | -0.78 | -0.58 | -1.04 | -0.11 | -1.45 |
| Nucleus | -6.47 | 83.89* | 65.08* | 53.22* | -0.63 | 6.36 | 126.51* | 107.22* | 96.08* | -8.50 | -0.40 | 141.53* | 118.29* | 109.08* | -6.64 |
| Peroxisomes | -1.03 | -12.73 | -6.52 | 0.93 | 5.98 | 0.90 | -1.75 | -2.97 | -5.80 | -2.13 | -0.97 | -7.56 | -5.04 | 0.16 | 0.93 |
| Vacuole | -0.50 | -56.48* | -25.48 | -25.43 | -3.42 | -3.84 | -77.44* | -38.36 | -37.98 | 19.79 | -2.46 | -88.56* | -44.96 | -44.69 | 10.70 |
| Vacuole Periphery | 0.98 | -0.49 | -1.46 | -5.43 | -2.41 | 0.85 | -2.69 | -1.16 | -6.29 | 2.45 | 1.26 | -2.24 | -1.42 | -7.92 | 1.73 |
Endocytosis
| Temp | Actin Patch (Sac6-tdTomato) | Cortical Patch (Sla1-GFP) | Late Endosome (Snf7-GFP) | Vacuole (Vph1-GFP) |
|---|---|---|---|---|
| 37℃ | ||||
| RT |
Cell Cycle Omics
CYCLoPs (Tdh2-GFP)
| Gene / Allele | Actin Patch (Sac6-tdTomato) | Cortical Patch (Sla1-GFP) | Late Endosome (Snf7-GFP) | Vacuole (Sac6-tdTomato) |
|---|
| Gene | Images |
|---|
| Gene | Images |
|---|
Images are not yet available
Images are not yet available